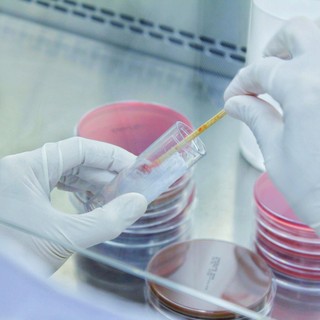
Mire utal a gennyes köpet? című cikk nyitóképe

Gennyes köpet
Mire utal a gennyes köpet?
A gennyes köpet a légutakból felszakadó nyákos váladék, amely sárgás, zöldes vagy barnás színű, és gyakran sűrű, viszkózus állagú. A jelenléte fertőzésre vagy gyulladásos folyamatra utalhat a légutakban, például tüdőgyulladás, hörghurut vagy más légúti betegségek esetén.
A gennyes köpet jellemzői
- Színe: sárgás, zöldes vagy barnás (ritkábban véres csíkokat is tartalmazhat)
- Állaga: sűrű, tapadós, esetenként habos
- Szaga: kellemetlen vagy bűzös (pl. tüdőtályog esetén)
- Mennyisége: változó, lehet napi néhány millilitertől akár nagyobb mennyiségig
A gennyes köpet lehetséges okai
A köpet színe és állaga alapján gyakran következtetni lehet az alapbetegségre:
Fertőzések
- Bakteriális tüdőgyulladás (Streptococcus pneumoniae, Haemophilus influenzae)
- Hörghurut (bronchitis) – akut vagy krónikus formában
- Tüdőtályog – gennyel telt üreg a tüdőben
- Tuberkulózis (TBC) – esetenként véres, gennyes köpet kíséri
Krónikus tüdőbetegségek
- Krónikus obstruktív tüdőbetegség (COPD) – gyakran sárgás vagy zöldes köpet
- Bronchiectasia – a hörgők kitágulásával járó állapot, bőséges gennyes köpetürítéssel
- Cisztás fibrózis – genetikai betegség, amely vastag, nehezen ürülő nyákképződéssel jár
Gombás fertőzések
Pl. Aspergillosis, amely gyakran érinti a legyengült immunrendszerű betegeket
Dohányzás és szennyezett levegő
A dohányzás következtében krónikus hörghurut alakulhat ki, amely sárgás vagy barnás köpetet eredményezhet
Ilyen vizsgálatokkal deríthető ki a gennyes köpet oka
Ha tartósan fennáll a gennyes köpet, vagy egyéb tünetekkel – például láz, mellkasi fájdalom, légszomj – társul, érdemes orvoshoz fordulni. A következő vizsgálatok segíthetnek az okok azonosításában:
- Köpetvizsgálat (mikrobiológiai tenyésztés, Gram-festés)
- Mellkasröntgen (tüdőgyulladás, tályog vagy egyéb kóros elváltozások kimutatására)
- Mellkasi CT-vizsgálat (ha részletesebb képalkotás szükséges)
- Légzésfunkciós vizsgálatok (pl. COPD gyanúja esetén)
- Bronchoszkópia (a légutak közvetlen vizsgálata endoszkópos módszerrel)
A kezelés az alapbetegségtől függően változik
- Antibiotikumok – bakteriális fertőzések esetén (pl. amoxicillin, makrolidok)
- Mukolitikumok (nyákoldók) – pl. acetilcisztein, karbocisztein, bromhexin
- Bronchodilatátorok – légutakat tágító gyógyszerek COPD vagy asztma esetén
- Gombaellenes szerek – ha gombás fertőzés áll a háttérben
- Dohányzás abbahagyása – a légutak irritációjának csökkentésére
- Megfelelő hidratáció – a köpet felhígításához és könnyebb felköhögéséhez
- Fizikoterápia, légzőgyakorlatok – pl. mellkasi fizioterápia bronchiectasiában szenvedők számára
Gyakori kérdések a gennyes köpetről
Előfordulhat, hogy betegségek, fertőzések hatására megnő a termelt váladék mennyisége (ez egészséges embereknél napi 1 liter is lehet), megváltozik az állaga, a színe.
A gennyes köpet mindig fertőzésre utal?
Nem feltétlenül, de gyakran bakteriális fertőzések, például tüdőgyulladás vagy hörghurut jele. Krónikus légúti betegségekben, például COPD-ben vagy bronchiectasiában is előfordulhat, anélkül hogy akut fertőzés állna a háttérben.
Milyen színű köpet jelez súlyos betegséget?
A sárga vagy zöld köpet bakteriális fertőzésre utalhat, míg a véres vagy barnás köpet súlyosabb állapotot, például tüdőtályogot, tuberkulózist vagy tüdődaganatot is jelezhet. Ha tartósan fennáll vagy rosszabbodik, orvosi vizsgálat szükséges.
Mit tehetek otthon a gennyes köpet ellen?
Fontos a bőséges folyadékfogyasztás, a nyákoldó szerek (orvosi ajánlás szerint) és a dohányzás elhagyása. Ha fertőzés áll a háttérben, az antibiotikumokat orvos írhatja fel. A rendszeres köhögési technikák és légzőgyakorlatok segíthetik a köpet kiürítését.
Mikor kell orvoshoz fordulni?
Ha a gennyes köpet több mint két hétig fennáll, magas láz, légszomj vagy mellkasi fájdalom társul hozzá, illetve ha véres köpet jelentkezik, mielőbbi orvosi vizsgálat javasolt.
Hogyan lehet megelőzni a gennyes köpet kialakulását?
A rendszeres kézmosás, a dohányzás kerülése, az influenza és pneumococcus elleni védőoltások, valamint a krónikus légzőszervi betegségek megfelelő kezelése segíthet megelőzni a gennyes köpethez vezető fertőzéseket és gyulladásokat.
Felhasznált források:
- Országos Gyógyszerészeti és Élelmezés-egészségügyi Intézet (OGYÉI)
- Centers for Disease Control and Prevention (CDC)
- Mayo Clinic
- MedlinePlus
- Cochrane Library